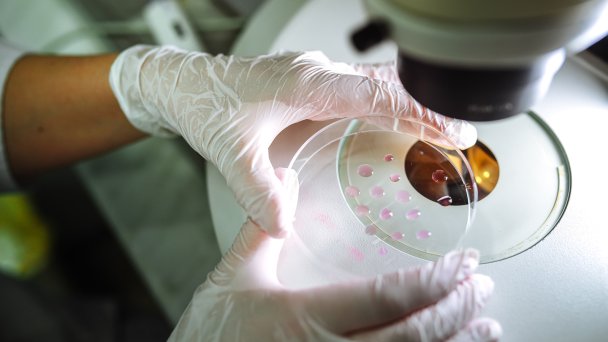

В погоне за оригинальностью: какие инновационные препараты разрабатывают в России
На инновационные лекарства самые большие надежды в медицине. Это принципиально новая «молекула», которая дает возможность достигнуть ранее недостижимое — определенные клинические цели, не доступные с помощью других лекарств, контроль над заболеванием, излечение, длительную ремиссию или переход из смертельно опасной формы в хроническую.
Появлению инновационного препарата предшествует период разработки длиной до 10 лет. Фундаментальные исследования иногда увеличивают этот срок, как это было с прорывным российским препаратом «Трибувиа».
Разработка оригинального лекарства включает много этапов, среди них отбор «молекулы» из нескольких кандидатов, эксперименты, разработка готовой лекарственной формы и исследования ее стабильности, создание технологии производства, строго регламентированный этап испытаний на животных и несколько этапов оценки безопасности и эффективности у людей.
В случае векторных вакцин или генотерапевтических препаратов это выбор наилучшего «транспорта» (вектора), который доставит «материал» в клетки, и встраивание его в вектор. Сейчас этот процесс стандартизуют путем создания платформ — готового модуля для быстрой разработки вакцин и препаратов.
Создание вакцины «Спутник V» в рекордные семь месяцев — особый случай. Помимо уникальных компетенций Центра им. Гамалеи, этому способствовал предшествующий опыт создания трех векторных вакцин против вируса Эбола и помощь 48 Центрального научно-исследовательского института (48 ЦНИИ) Министерства обороны. Ведомственный институт специализируется на разработке препаратов против особо опасных инфекций и к тому моменту зарегистрировал уже семь вакцин.
Создание нового лекарства, которое вводится в организм человека впервые, связано со значительными финансовыми вложениями. Инвестиции в оригинальные инновационные препараты могут начинаться от 1 млрд рублей, поясняют в компании «Биокад».
Самый затратный этап — клинические исследования, уточняют в «Генериуме», часто они требуют более 50% бюджета разработки, в случае онкологических препаратов — до 80%.
Каждый этап сопряжен с риском, который приведет к тому, что лекарство зарегистрировано не будет. Отзывы с рынка спустя несколько лет после регистрации и активного применения из-за неожиданно полученных данных о безопасности или повышенного риска заболевания тоже случаются. Так произошло с иностранными препаратами Viox компании MSD, Meridia от Abbot, Katadolon от Teva, Champix/Chantix от Pfizer.
Это объясняет, почему среди оригинальных российских лекарств велика доля препаратов, разработанных государственными институтами и центрами с бюджетным финансированием.
Государственная привилегия
В последние десятилетия российская фарма концентрировалась на регистрации дженериков. Доля их на российском рынке стабильно высока: 96,4–97,3% в упаковках за последние четыре года, сообщает DSM.
Оригинальные российские лекарства появлялись, но часто это были вакцины и другие иммунобиологические препараты, за которыми стояли государственные институты и структуры Министерства обороны.
В России создание вакцин исторически было привилегией государственных компаний. Входящему в госкорпорацию «Ростех» НПО «Микроген» принадлежат регистрационные удостоверения более 20 вакцин. Это один из основных поставщиков вакцин из Национального прививочного календаря и зарегистрированных в России аллергенов. Вакцины для национального календаря выпускают также другие государственные институты.
Разработка вакцин в пандемию COVID-19 шла по аналогичному сценарию. Фактически 12 зарегистрированных российских «ковидных» вакцин разработали четыре государственных института: Центр им. Гамалеи, ГНЦ ВБ «Вектор», Федеральный научный центр исследований и разработки иммунобиологических препаратов им. Чумакова и Санкт-Петербургский НИИ вакцин и сывороток. Только на одну вакцину регистрационное удостоверение получила компания «Генериум» — назальный «Салнавак», но спустя три года добровольно отозвала ее с рынка.
Противоположная ситуация складывалась в мире. Из 50 одобренных «ковидных» вакцин (за исключением российских препаратов) только пять созданы в государственных институтах, две — при сотрудничестве с ними.
Пандемия стала катализатором серьезных изменений в отрасли. Когда были осознаны угрозы ее повторения, в России стартовал федеральный проект «Санитарный щит» для защиты от биологических угроз и началось создание «Российской научно-технологической платформы оперативного реагирования на инфекционные заболевания». Плюс к этому пандемия привела к всплеску разработок социально значимых лекарств и платформенных технологий.
Против особо опасных
Помимо гражданских институтов, созданием вакцин для защиты от особо опасных инфекций в России занимается и 48 ЦНИИ Минобороны. Это единственный поставщик иммунобиологических препаратов против сибирской язвы в стране, поставляет 15 000–20 000 упаковок в год.
Учитывая задачи института в обеспечении защиты армии и населения от особо опасных инфекций, понятно, почему половина вакцин разработана в необычной, но наиболее приемлемой для массовой иммунизации населения форме таблеток.
Такой выбор разработчики из 48 ЦНИИ объясняют в журнале «Проблемы особо опасных инфекций» невозможностью в ряде случаев проводить массовую иммунизацию в медицинских учреждениях. Для этого лучше подходят пероральные вакцины в таблетках, которые могут применяться дома, в учреждениях, на транспорте, когда для контроля приема препарата достаточно минимального количества медперсонала. Сейчас институт владеет регистрационными удостоверениями семи вакцин и иммуноглобулина против сибирской язвы.
В 2023 году институт Минобороны сообщил о разработке первой вакцины против сибирской язвы в капсулах, ранее зарегистрировав две «традиционные» для подкожного введения. В экспериментах даже однократное введение капсул давало защиту 70% животных от высоковирулентного штамма сибирской язвы.
Институт Минобороны также ведет разработку новой вакцины против оспы «ТЭОВин» в жевательных таблетках, которая относится к последнему поколению препаратов. Это инактивированная вакцина (вакцина, в которой возбудитель «обезврежен» и не способен вызвать инфекцию), поэтому может применяться у ранее не привитых от оспы людей без риска осложнений и реакций, которые можно ожидать от живой вакцины. В условиях завершения вакцинации против оспы в 1979–1980 годах это особенно важно.
На фоне сообщений ВОЗ о появлении гибридного вируса оспы обезьян и выявлении завозных случаев в России 48 ЦНИИ впервые выпустил в гражданский оборот семь серий вакцины против оспы «ТЭОВак» в жевательных таблетках, следует из реестра Росздравнадзора.
Разработкой препаратов против натуральной оспы и родственных вирусов занимается также новосибирский ГНЦ ВБ «Вектор». Четыре года назад центр зарегистрировал вакцину «ОртопоксВак» и лекарство «НИОХ-14» для профилактики и лечения оспы у взрослых.
Российский препарат от оспы «НИОХ-14» — пролекарство. Оно не активно само по себе, но при попадании в организм в процессе биотрансформации из него образуется активный метаболит — тековиримат, который обладает противовирусными свойствами. Именно тековиримат является действующим веществом TPOXX — лекарства от оспы, одобренного в 2018 году в США, странах ЕС и Канаде.
После успеха «Спутника» Центру Гамалеи дали зеленый свет на разработку вакцин и препаратов. На разных этапах исследований находятся векторная вакцина «2 в 1» от двух самых смертельных вирусов в мире — Эбола и Марбург, моноклональные антитела для экстренной профилактики лихорадки Эбола и иммуноглобулин, вакцина против высокопатогенного коронавируса, вызывающего ближневосточный респираторный синдром.
Вторую «ковидную» вакцину Центр Гамалеи создал, используя принципиально новую технологию вирусоподобных частиц. Нужные белки собирают, как конструктор, в одну структуру. Это дает возможность «добавлять» ключевые структуры самых разных вариантов возбудителя. Сейчас «Гам-VLP-мультивак» содержит структуры сразу четырех вариантов коронавируса — первого уханьского, Альфа, Дельта и Омикрона. При необходимости их можно заменять на другие. Минздрав зарегистрировал «Гам-VLP-мультивак» сразу в двух формах: для привычного внутримышечного введения и назальных капель.
Против социально значимых заболеваний
Пандемия, помимо осознания необходимости быть готовыми к инфекционным угрозам, дала мощный толчок к разработкам лекарств для социально значимых заболеваний, серьезный ущерб от которых связан с инвалидностью и серьезными затратами на их лечение. И если выбор препаратов для лечения артериальной гипертензии или диабета достаточный, потребность в новых антибиотиках или вакцине против туберкулеза высока как никогда.
Единственная в мире вакцина против туберкулеза БЦЖ появилась сто лет назад. Стремительное развитие технологий, появление векторных вакцин и начало прививок генами («Спутник V» доставляет ген белка коронавируса) не помогло решить две насущные проблемы — создать вакцину против ВИЧ и новую вакцину против туберкулеза. БЦЖ хорошо защищает детей, но со временем защита падает. На подростков и взрослых приходится до 90% случаев туберкулеза.
Центр Гамалеи разработал новую вакцину «ГамТБвак», которая содержит белки возбудителя туберкулеза. Исследования идут более 10 лет, последняя фаза, по данным ГРЛС, должна завершиться в 2026 году. Это не значит, что при регистрации новой противотуберкулезной вакцины она заменит БЦЖ.
Тревожная ситуация складывается с разработкой новых антибиотиков. Потенциальный риск быстрого развития устойчивости бактерий к новому препарату снижает желание производителей инвестировать в разработку инновационных антибактериальных лекарств. За семь лет, с 2017 по 2023 год, в мире одобрено только два инновационных антибиотика, сообщает ВОЗ. Третий, зарегистрированный в 2024 году, Центр Гамалеи создал с абсолютно новым механизмом действия. Первый в своем классе антимикробный препарат «Фтортиазинон» не убивает бактерии, а лишает вирулентности — способности вызывать заболевания. Препарат «работает» против самых тяжелых возбудителей, часто устойчивых к другим препаратам.
На российском рынке в 2024 году стали доступны только два новых антибиотика. Один — «Фтортиазинон» Центра Гамалеи, другой — цефалоспорин V поколения «Зевтера» швейцарской компании Basilea Pharmaceutica.
В последние годы в России наметился тренд — союз академической науки, отвечающей за фундаментальную научную составляющую, и фармкомпании, которая завершает разработку «молекулы» академического института и выводит лекарство на рынок.
Такой «тандем» науки и бизнеса наблюдали при выводе на рынок инновационного лекарства для лечения болезни Бехтерева — «Трибувиа». Этот препарат разработан научной группой под руководством академика Сергея Лукьянова, на рынок его вывел российский производитель «Биокад». Учитывая, что это первый в своем классе препарат и потенциально прорывная терапия, Минздрав разрешил его быстрый доступ на рынок.
Аналог «Трибувиа» начали разрабатывать в западных странах, сообщил на IX съезде ревматологов в июле 2025 года академик Лукьянов. По его словам, такая ситуация, когда Россия была первой в разработке сложного препарата от редкого заболевания, сложилась впервые в новейшей истории. В «Биокаде» не исключают регистрацию «Трибувиа» на международных рынках.
Такое партнерство в перспективе способно решить потребности обеих сторон, считают в компании. Академическая среда нуждается в реализации научных проектов, экспертизе при разработке препаратов, проведении клинических исследований и регистрации. А бизнес, опираясь на убедительные фундаментальные исследования от научного партнера, фокусируется на разработке «молекул», клинических исследованиях и выводе на рынок.
Второй союз сложился между Институтом иммунологии ФМБА, который с приходом молодого руководителя активно включился в процесс разработки инновационных лекарств и аллерговакцин, и российской компанией «Генериум».
Вакцины от аллергии — абсолютно новое явление не только для российской, но и для мировой медицины. Они заставляют организм страдающего аллергией человека, переключать иммунный ответ с аллергического на обычный, вырабатывая обычные защитные антитела IgG вместо «особых» — IgE, которые и дают аллергические реакции. В процессе регистрации находится вакцина «Аллергарда» против аллергии на пыльцу березы.
Сейчас Институт иммунологии ведет разработку другой аллерговакцины — против аллергии на амброзию, сообщил его директор академик Муса Хаитов на «Форуме будущих технологий» 26 февраля. Быстрое создание второй аллерговакцины стало возможным после создания специальной платформы.
Платформы — хорошо изученные, стандартизованные и воспроизводимые технологии и процессы, которые позволяют быстро получать новые вакцины и препараты. Платформы упрощают процесс разработки и сокращают время по сравнению с созданием лекарств с нуля.
Ключевое преимущество платформ — в создании универсальной технологической основы, которую можно быстро адаптировать под новый патоген или терапевтическую мишень, объясняет директор Центра Гамалеи академик Денис Логунов. Использование платформ существенно сокращает время разработки препарата. Когда базовая технология отработана, для создания новой вакцины необходимо лишь заменить генетическую последовательность, кодирующую нужный антиген. При использовании платформы ранние стадии разработки могут занимать всего несколько месяцев: получить готовый вакцинный кандидат можно в течение нескольких недель после расшифровки генома возбудителя. В экстренных эпидемиологических ситуациях это может уменьшить срок создания вакцины с 10–15 до 1–2 лет или даже меньше, что делает такие технологии ключевыми для быстрого реагирования на новые инфекционные угрозы.
Центр Гамалеи исповедует платформенную идеологию, рассказал Денис Логунов на «Форуме будущих технологий». Разработаны субъединичные, вирусоподобные, векторные платформы на основе аденовирусов и аденоассоциированных вирусов, рабдовирусов. Сейчас Центр разрабатывает мРНК-платформу. Она позволяет создавать вакцины нового поколения, в которых используется матричная РНК, кодирующая антиген. На базе этой платформы получено несколько препаратов для профилактики инфекционных заболеваний (клещевого энцефалита, гриппа, COVID-19 и др.), которые сейчас на стадии доклинических исследований.
В Институте иммунологии созданы две платформы, сообщил академик Муса Хаитов на том же форуме. Помимо платформы для создания аллерговакцин, о которой мы уже говорили, создана платформа, которая использует технологию интерференции РНК. За открытие этого феномена в 2006 году американские ученые Файер и Мэллоу получили Нобелевскую премию. Малую интерферирующую РНК (миРНК) можно использовать для подавления практически любой мишени, включая вирусы, объяснил Муса Хаитов.
Подход впервые использовала компания «Новартис» в первом в своем классе препарате «Сибрава», одобренном в 2020 году в мире, два года спустя — в России. Блокируя ключевой белок с помощью миРНК, существенно снижается уровень атерогенного, так называемого плохого, холестерина в организме.
Этот же принцип использован Институтом иммунологии при создании препарата «МИР 19» для лечения COVID-19, где миРНК направлена против жизненно важного для размножения коронавируса белка. Используя платформу и технологию интерференции РНК, Институт иммунологии уже разработал «профильные» препараты для терапии аллергического ринита и бронхиальной астмы, блокирующие интерлейкин-4 и интерлейкин-13 — основные молекулы аллергического воспаления. Это ингаляционные лекарства, доклинические исследования которых завершены. Институт также ведет разработку лекарства для лечения орфанного заболевания — наследственного ангионевротического отека — и препарата против атеросклероза.
Лекарства от редких заболеваний
Исторически обеспечение орфанными препаратами (препаратами против редких заболеваний) в России происходило за счет иностранных лекарств. Российских игроков сдерживали высокая стоимость разработки и ограниченный рынок сбыта.
Работа в сегменте орфанных лекарств — одно из наиболее сложных направлений в биотехнологиях, объясняют в «Генериуме». Но, несмотря на объективные сложности, в России год от года увеличивается число зарегистрированных орфанных лекарств. Если в 2022 году выдано три регистрационных удостоверения, в 2024-м уже девять. Разработкой и выводом на рынок биоаналогов и инновационных орфанных лекарств занимаются российские компании «Генериум», «Биокад», «Р-Фарм» и некоторые другие.
«Генериум» сформировал портфель более чем из 20 биотехнологических препаратов. Они относятся к сложным продуктам орфанного сегмента, которые ранее не производились в России. Среди них и собственная разработка для лечения редкого наследственного синдрома Хантера «Клотилия». Это первое в мире лекарство в своем роде. Оно позволяет воздействовать на процессы в нервной системе, на когнитивные способности пациентов. Собственная оригинальная разработка «Биокада» — «следующий в классе» геннотерапевтический препарат для лечения гемофилии В — арвенакоген санпарвовек. Для его создания потребовалось сначала разработать специальную платформу. Препарат проходит процедуру регистрации в Минздраве. Для лечения редкого идиопатического перикардита, в основе которого избыточный синтез молекулы, поддерживающей воспаление, в России зарегистрирован «Арцерикс» — собственная разработка компании «Р-Фарм».
Помощь государства
Минпромторг разрабатывает меры поддержки отечественных компаний с компенсацией затрат на клинические исследования. Об этом сообщил глава Минпромторга Антон Алиханов на совещании президента России Владимира Путина с членами правительства в январе 2026 года. Это касается первых в своем классе лекарств и препаратов, которые превзошли существующие методы лечения.
Для крупных игроков это шанс вырасти в глобальные фармкомпании, для средних и малых — возможность привлечь финансирование под прорывные идеи, считают в «Генериуме». Однако успех будет зависеть от четкого и прозрачного определения критериев отбора препаратов и от выбора механизма компенсаций.
